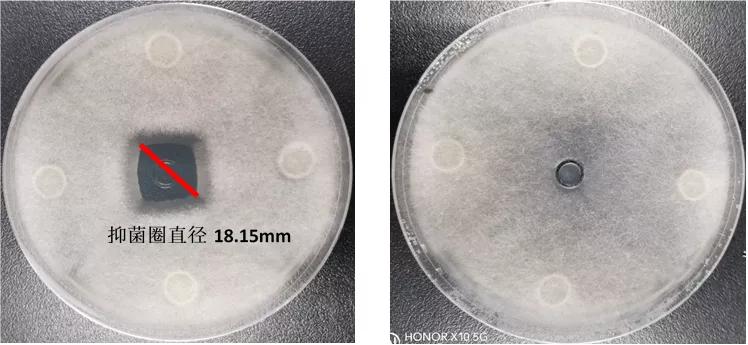
不同源水霉菌区别这么大？怎么有效防治？来看高手详解
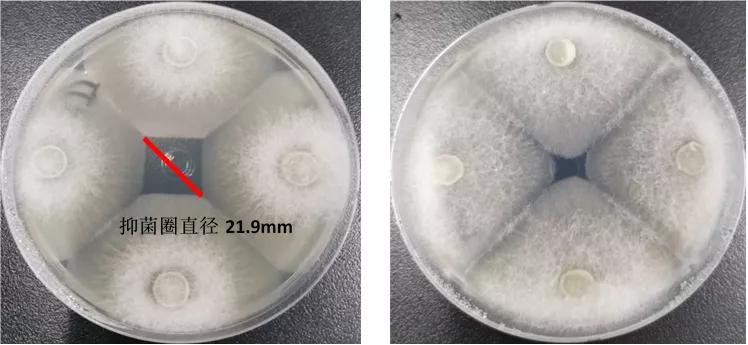
不同源水霉菌区别这么大？怎么有效防治？来看高手详解

水霉病是由水霉菌引起的真菌性疾病,对水生动物种类没有选择性,凡受伤的机体和卵均可被感染致病。病鱼出现焦躁不安、食欲减退、体质下降、行动迟缓,最终瘦弱而死。水霉病的发生严重影响养殖效益。
在我国淡水水产动物中的体表和卵上共发现的水霉有十多种,引起水霉病的病原体现已发现的有十多种,最常见的病原是多种水霉和绵霉。水霉菌的繁殖方式是通过孢子进行无性繁殖,水霉孢子在自然环境大量存在,对环境耐受性极强,对温度适应范围很广。当水温低于20℃时水霉病原菌适宜繁殖,其最适繁殖温度为10-18℃,水霉菌在15℃左右时生长最活跃,水温高于28℃才能抑制孢子繁殖。因此,水霉病并不是只有冬季低温期发生,水温低于20℃都要防治该病的发生。
如何有效防治水霉病?选择有效防治水霉病的药物很关键。
防治水霉病的药物有很多种,如何选择有效药物直接决定了防治效果。防治水霉病的药物可以分为抑菌型的主要用于预防,如硫醚沙星等,主要是抑制水霉菌的生长,一旦观察到白毛菌丝,如果不能杀菌是没有治疗效果的;有去除菌丝性和恢复伤口型的,如五倍子、水杨酸等,主要用于脱落菌丝和收敛伤口,不能杀灭水霉,也起不到治疗效果;一种是治疗型的,具有杀菌效果,可以杀灭水霉菌,具有真正的治疗效果。菌霉净融合了五倍子提取物收敛伤口和杀灭病原水霉菌的双重效果具有很好的防治水霉病效果。
药敏实验是验证一种消毒产品对抗细菌或真菌的敏感性实验。为了验证 菌霉净 对水霉菌的敏感性和防治效果,委托华中农业大学进行了药敏实验验证。针对不同源的水霉菌共设计了四个实验:
实验一是验证对鲫鱼卵来源的水霉菌的敏感性,牛津杯分别加入1000倍稀释的菌霉净和无菌水,加菌霉净的抑菌圈直径为18.15毫米;
实验二是验证对鲫鱼来源的水霉菌的敏感性,牛津杯分别加入1000倍稀释的菌霉净和无菌水,加菌霉净的抑菌圈直径为25.20毫米;
实验三是验证对标准水霉菌菌株的敏感性,牛津杯分别加入1000倍稀释的菌霉净和无菌水,加菌霉净的抑菌圈直径为15.20毫米;
实验四是验证对斑马鱼来源水霉菌的敏感性,牛津杯分别加入1000倍稀释的菌霉净和无菌水,加菌霉净的抑菌圈直径为21.90毫米;
实验结果表明, 菌霉净 对不同来源的水霉病菌都很敏感,稀释1000倍的 菌霉净 最大抑菌圈直径达25.20毫米,最小抑菌圈直径15.20毫米。
这个实验也表明, 菌霉净 对不同来源的水霉菌敏感性不同。可能不同源水霉菌有一定变化,这也指导我们防治水霉病时用药量要有一定变化,同样的药物防治不同鱼源的水霉病效果也不一定一样。

实验一、菌霉净对鲫鱼卵水霉菌抑菌实验

实验二、菌霉净对鲫鱼源水霉菌抑菌实验

实验三、菌霉净对标准水霉菌抑菌实验
实验四、菌霉净对斑马鱼源水霉菌抑菌实验
本文来源 :华扬水产, 转载请注明出处。